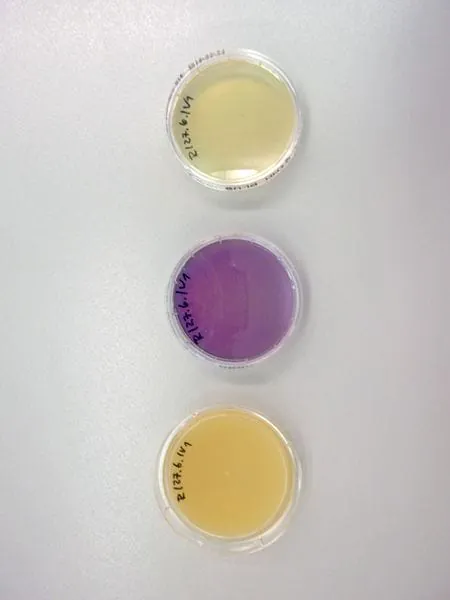
Mit Wasser und Spezialpads gegen Mikroorganismen

Reinigung patientenferner Bereiche Mit Wasser und Spezialpads gegen Mikroorganismen
Mit Scheuersaugmaschine, Diamanten besetzten Pads und klarem Wasser gegen Bakterien? In einer Bachelor-Thesis untersuchte Renè Hein in patientenfernen Bereichen eines Krankenhauses die herkömmliche Reinigung und die Reinigung mit Wasser und Spezialpads auf ihre Wirksamkeit gegen Keime und Bakterien.
› mehr